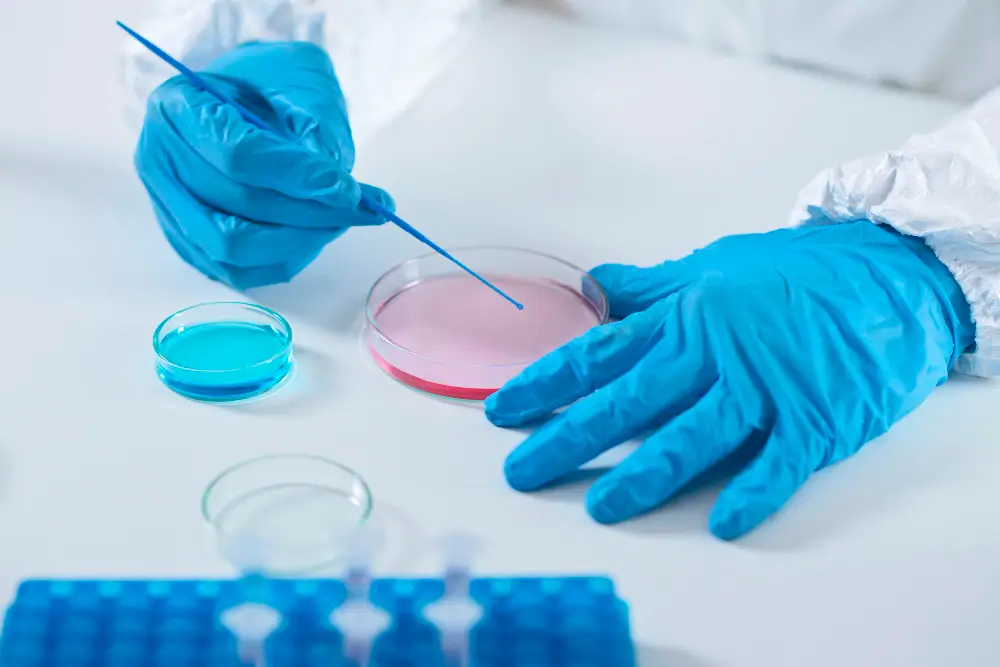

Preserve Your Fertility with Egg Freezing
A Life-Changing Decision
In today’s fast-paced world, women are constantly juggling personal goals, careers, and everything in between. The idea of starting a family often takes a backseat, but what if you could secure your future without compromising your dreams? Many women begin this journey by asking how much is egg freezing costs, and whether it’s the right step for their long-term plans.
Egg freezing is an empowering option for those who want to extend their fertility and preserve their chances of having biological children at a later time. It’s a proactive step that offers flexibility and peace of mind, especially for women who are not yet ready to start a family but may want to in the future.
At Gateway Surrogacy, we understand the importance of having control over your fertility, and we’re here to guide you every step of the way. As a trusted egg freezing clinic in NJ, our egg freezing services allow you to make the decision that works best for your future, on your own timeline.
Why Consider Freezing Your Eggs?
Egg freezing, also known as oocyte cryopreservation, is a revolutionary option that allows women to preserve their eggs for future use. Understanding the egg freezing process can help you feel more confident about this decision. There are several reasons why women consider freezing their eggs:
- Postponing Parenthood: Sometimes, life takes unexpected turns. Whether it’s focusing on your career, completing your education, or finding the right partner, egg freezing allows you to delay starting a family without the pressure of a ticking biological clock.
- Health and Age Considerations: As you age, the quality and quantity of your eggs naturally decline. Freezing your eggs at a younger age increases the likelihood of a successful pregnancy later in life. Egg freezing can give you a better chance of achieving your dream of parenthood when the time is right for you.
- Medical Treatments: Some women may choose to freeze their eggs due to medical reasons, such as undergoing chemotherapy, radiation, or other treatments that could affect fertility. Egg freezing ensures that their fertility options remain intact, even during or after medical procedures.

Our Egg Freezing Process: Simple, Secure, and Stress-Free
Why Choose Us for Egg Freezing?
At Gateway Surrogacy, we provide more than just a service – we offer support, guidance, and peace of mind throughout the entire journey. Here’s why we’re the trusted choice for women considering this important step
Personalized Care
We believe that fertility is personal. From your first consultation to your egg retrieval, we tailor our approach to meet your unique needs. Our fertility experts take the time to understand your concerns and provide a compassionate, individualized plan.
State-of-the-Art Technology
Our clinic uses the latest technology and techniques to ensure the highest success rates for egg freezing. With our cutting-edge cryopreservation methods, you can rest assured that your eggs will be stored safely and securely for as long as needed.
Experienced Team
Our team of fertility specialists, nurses, and counselors is here to support you at every stage of the process. With years of experience in fertility preservation and assisted reproductive technologies, we’ve helped countless women make empowered decisions about their future.
Confidential and Compassionate Support
We know that this is a deeply personal decision, and we approach each case with empathy, respect, and confidentiality. We are committed to providing a safe, non-judgmental space for women to explore their fertility options.
Is Egg Freezing Right for You?
If you’re wondering whether egg freezing is the right option, here are a few key questions to consider:
- Do you want to take control of your fertility and extend your options for future parenthood?
- Are you postponing starting a family due to career, personal, or other reasons?
- Do you have medical reasons or concerns that could affect your fertility?
If you answered yes to any of these, then egg freezing could be the perfect choice for you. It’s a way to ensure that you don’t have to compromise on your dreams, whether it’s building a career, completing your education, or starting a family when the time is right.

Frequently Asked Questions
A. Egg freezing involves stimulating your ovaries to produce multiple eggs, which are then retrieved and frozen for future use. Understanding how much is egg freezing costs is often part of the initial consultation, and it’s a way to preserve fertility if you’re not ready to start a family yet.
A. Your eggs can be stored for many years. Most clinics, including ours as a trusted egg freezing clinic in NJ, store eggs for as long as needed, ensuring they remain viable for future use when you’re ready to have children.
A. The egg freezing process involves hormone injections and a minor surgical procedure to retrieve the eggs. The egg retrieval is done under sedation, so you’ll feel no pain during the procedure.
A. We aim to retrieve as many eggs as possible during the stimulation process, typically around 10–20 eggs. This approach helps optimize outcomes while also considering the cost of egg freezing in New Jersey, which can vary based on the number of cycles needed.
A. Once your eggs are retrieved, they are frozen and stored in a secure, state-of-the-art facility until you’re ready to use them. We’ll keep in touch to update you on your eggs’ status and answer any questions you may have along the way.
Take the Next Step Towards Securing Your Future
We know how important it is to make the right decisions for your future, and we’re here to help you along the way. Whether you’re looking to freeze your eggs for medical reasons or to preserve your fertility for future use, we’re here to provide support, guidance, and expertise.
Don’t let time hold you back. Reach out to us today to schedule a consultation and take the first step towards securing your fertility future.
At Gateway Surrogacy, we’re here for you – every step of the way.
Please call (856) 565-2181, 551-666-5154 or email info@gatewaysurrogacy.org

Ready to take it a step further?
About Company
Gateway Surrogacy was founded in 2016 and registered in New Jersey. Our leaders have been through the surrogacy process themselves.
Useful Links
Get In Touch
- 525 NJ-73 #104, Marlton, NJ 08053
- (856) 565-2181
- 551-666-5154
- info@gatewaysurrogacy.org
- Mon – Fri: 9am - 6pm EST.
© 2024 - Gateway Surrogacy. All Right Reserved Developed by HC Technologies



